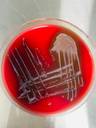
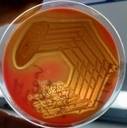

MAAT BIOTECH Polystyrene Disposable Petri Dish (90 mm Pack of 100)
Share
MAAT BIOTECH Polystyrene Disposable Petri Dish (90 mm Pack of 100)
Be the first to Review this product
Special price
₹5,754
₹10,422
44% off
Available offers
T&C
Warranty
PRODUCT SHOULD BE STORED , SHIPPED , DISPATCHED BASED ON THE TDS
Delivery
Check
Enter pincode
Delivery by10 Oct, Friday
?
if ordered before 3:59 PM
View Details
Highlights
- SHEEP BLOOD AGAR PLATE
Services
- PRODUCT SHOULD BE STORED , SHIPPED , DISPATCHED BASED ON THE TDS
- Cash on Delivery available?
Seller
Description
MAAT BIOTECH SHEEP BLOOD AGAR PLATES
Read More
Specifications
In The Box
| Pack of |
|
General
| Brand |
|
| Model Number |
|
| Material |
|
| Usage Type |
|
| Shape |
|
| Ventilation Rib Included |
|
| Number of Ventilation Ribs |
|
| Net Quantity |
|
Additional Features
| Compartmentalized |
|
| Lid Included |
|
| Certifications |
|
| Key Features |
|
| Other Features |
|
Dimensions
| Inner Diameter |
|
| Outer Diameter |
|
| Weight |
|
| Other Dimensions |
|
Warranty
| Warranty Summary |
|
| Service Type |
|
| Covered in Warranty |
|
| Not Covered in Warranty |
|
| Domestic Warranty |
|
Be the first to ask about this product
Safe and Secure Payments.Easy returns.100% Authentic products.
Back to top